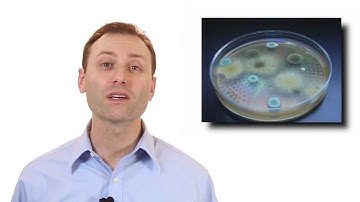
Groupings of Mold

⬇ DOWNLOAD NOW
Kalau muncul iklan pop-up, tutup lalu klik tombol kembali
Download lagu IAQA Tech Tip: Mold Remediation secara gratis hanya untuk keperluan promosi. Dukung artis favorit kamu dengan membeli musik original di iTunes atau platform resmi lainnya.
 Mold Remediation Guidance Documents
Mold Remediation Guidance Documents
 IAQA Tech Tip: Mold Inspections
IAQA Tech Tip: Mold Inspections
 Antimicrobial Use During Mold Remediation
Antimicrobial Use During Mold Remediation
 IAQA Tech Tip: Respirators
IAQA Tech Tip: Respirators
 Post Remediation Verification
Post Remediation Verification
 Removing Mold
Removing Mold
 IAQA Tech Tip: What's "Normal"
IAQA Tech Tip: What's "Normal"
Groupings of Mold
Groupings of Mold